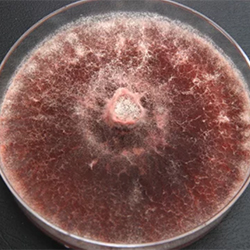

By Ethan Covey
Recent deaths among U.S. citizens who traveled to the Dominican Republic to undergo cosmetic surgery were associated with being overweight or suffering a venous thromboembolism, not infections, according to a recent report.

From 2009 to 2022, 93 Americans died after undergoing cosmetic surgery in the Dominican Republic. Although infections have frequently been reported after cosmetic procedures conducted outside of the United States, they have rarely resulted in deaths (MMWR Morb Mortal Wkly Rep 2024;73[3]:62-65).
The Dominican Republic has long been a popular destination for medical tourism due to its proximity to the United States, short wait times for procedures, tourism infrastructure and the fact that some of its doctors advertise in the United States.
The rate of deaths among Americans after cosmetic surgery in the DR increased from a mean of 4.1 per year during 2009-2018 to a mean of 13.0 during 2019-2022. Seventeen deaths—the highest number—were observed during 2020.
The report found that nearly all the people who died had an elevated body mass index and had received multiple procedures on a single day. Of the 20 fatalities that took place during 2019-2022 and had an available autopsy report, 90% were attributed to embolic phenomena. Additionally, 92% had personal and 100% had procedural risk factors for perioperative embolism.
“[This report] tells us that the deaths in U.S. citizens after cosmetic surgery in the Dominican Republic in 2019-2020 were mostly due to embolic events, including fat embolism and blood clots,” said Eliza-beth Bancroft, MD, a medical epidemiologist with the CDC.
“The risk of death can be lowered with good preoperative care, good operative techniques and careful decision making about the number and type of procedures that are performed at one time,” Dr. Bancroft said.
“This study did not find that lapses in infection control and prevention contributed to the deaths,” said Matthew Hudson, MD, an assistant professor of medicine at the Jacobs School of Medicine and Biomedical Sciences-University at Buffalo, in New York.
“However, when considering surgery within the U.S. and abroad, patients should be mindful that such infections can occur as both early and late complications of cosmetic surgery anywhere, and they should confirm that they are receiving care in facilities that perform regular infection prevention and control audits and have certification from national and/or international accreditation bodies related to healthcare quality assurance.”
The sources reported no relevant financial disclosures.